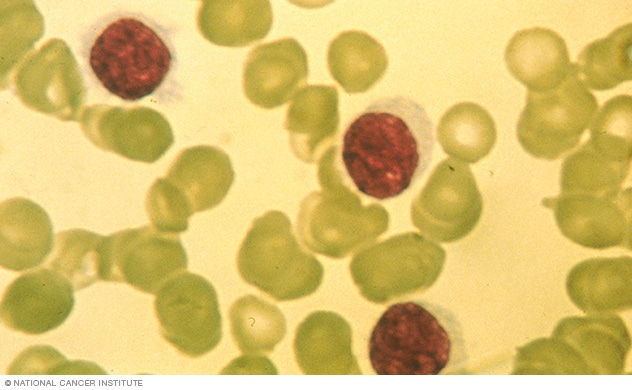
Haarzellleukämiezellen unter dem Mikroskop

Haarzell-Leukämie
Haarzell-Leukämie
Überblick
Haarzell-Leukämie
Haarzell-Leukämie
Haarzellige Leukämiezellen, die auf diesem Foto als dunklere Zellen erscheinen, sind von einem Heiligenschein aus feinen Vorsprüngen (Zotten) umgeben. Um Haarzellenleukämie zu diagnostizieren, kann Ihr Arzt eine Knochenmarkprobe aus Ihrem Körper entnehmen und unter einem Mikroskop auf Haarzellen untersuchen.
Haarzell-Leukämie ist ein seltener, langsam wachsender Blutkrebs, bei dem Ihr Knochenmark zu viele B-Zellen (Lymphozyten) produziert, eine Art weißer Blutkörperchen, die Infektionen bekämpfen.
Diese überschüssigen B-Zellen sind anormal und sehen unter dem Mikroskop „haarig“ aus. Mit zunehmender Anzahl von Leukämiezellen werden weniger gesunde weiße Blutkörperchen, rote Blutkörperchen und Blutplättchen produziert.
Haarzell-Leukämie betrifft mehr Männer als Frauen und tritt am häufigsten bei Erwachsenen mittleren Alters oder älteren Menschen auf.
Haarzell-Leukämie gilt als chronische Krankheit, da sie möglicherweise nie vollständig verschwindet, obwohl die Behandlung zu einer jahrelangen Remission führen kann.
Symptome
Manche Menschen haben keine Anzeichen oder Symptome einer Haarzellen-Leukämie, aber ein Bluttest für eine andere Krankheit oder einen anderen Zustand kann versehentlich eine Haarzellen-Leukämie aufdecken.
In anderen Fällen treten bei Menschen mit Haarzellenleukämie Anzeichen und Symptome auf, die für eine Reihe von Krankheiten und Zuständen typisch sind, wie zum Beispiel:
- Ein Völlegefühl in Ihrem Bauch, das es unangenehm machen kann, mehr als ein bisschen auf einmal zu essen
- Ermüdung
- Leichte Blutergüsse
- Wiederkehrende Infektionen
- Die Schwäche
- Gewichtsverlust
Wann zum arzt
Vereinbaren Sie einen Termin mit Ihrem Arzt, wenn Sie anhaltende Anzeichen und Symptome haben, die Sie beunruhigen.
Ursachen
Es ist nicht klar, was Haarzell-Leukämie verursacht.
Ärzte wissen, dass Krebs entsteht, wenn Zellen Fehler (Mutationen) in ihrer DNA entwickeln. Im Fall der Haarzell-Leukämie führen Mutationen in der DNA dazu, dass Ihre Knochenmarkstammzellen zu viele weiße Blutkörperchen bilden, die nicht richtig funktionieren. Ärzte wissen nicht, was die DNA-Mutationen verursacht, die zu Haarzell-Leukämie führen.
Risikofaktoren
Bestimmte Faktoren können Ihr Risiko für die Entwicklung einer Haarzell-Leukämie erhöhen. Nicht alle Forschungsstudien stimmen darin überein, welche Faktoren Ihr Krankheitsrisiko erhöhen.
Einige Forschungsergebnisse deuten darauf hin, dass Ihr Risiko für Haarzell-Leukämie aufgrund Ihrer:
- Strahlenbelastung. Personen, die Strahlung ausgesetzt sind, wie z. B. Personen, die in der Nähe von Röntgengeräten arbeiten und keine angemessene Schutzausrüstung tragen, oder Personen, die eine Strahlenbehandlung gegen Krebs erhalten haben, haben möglicherweise ein höheres Risiko, an Haarzellenleukämie zu erkranken, aber die Beweise sind nicht schlüssig.
- Exposition gegenüber Chemikalien. Es gibt widersprüchliche Studien zur Rolle von Industrie- und Agrarchemikalien bei der Entstehung von Haarzellenleukämie.
Komplikationen
Die Haarzell-Leukämie schreitet sehr langsam voran und bleibt manchmal über viele Jahre stabil. Aus diesem Grund treten nur wenige Komplikationen der Krankheit auf.
Unbehandelte Haarzell-Leukämie, die fortschreitet, kann gesunde Blutzellen im Knochenmark verdrängen, was zu schwerwiegenden Komplikationen führen kann, wie zum Beispiel:
- Infektionen. Eine verringerte Anzahl gesunder weißer Blutkörperchen setzt Sie dem Risiko von Infektionen aus, die Ihr Körper ansonsten abwehren könnte.
- Blutung. Niedrige Blutplättchenzahlen machen es Ihrem Körper schwer, Blutungen zu stoppen, wenn sie einmal begonnen haben. Wenn Sie eine leicht niedrige Blutplättchenzahl haben, werden Sie möglicherweise feststellen, dass Sie leichter blaue Flecken bekommen. Sehr niedrige Blutplättchenzahlen können zu spontanen Nasen- oder Zahnfleischbluten führen.
- Anämie. Eine niedrige Anzahl roter Blutkörperchen bedeutet, dass weniger Zellen verfügbar sind, um Sauerstoff durch Ihren Körper zu transportieren. Dies wird als Anämie bezeichnet. Anämie verursacht Müdigkeit.
Erhöhtes Risiko für Zweitkrebs
Einige Studien haben ergeben, dass Menschen mit Haarzell-Leukämie möglicherweise ein erhöhtes Risiko haben, an einer zweiten Krebsart zu erkranken. Es ist nicht klar, ob dieses Risiko auf die Wirkung der Haarzellen-Leukämie auf den Körper zurückzuführen ist oder ob das Risiko von den Medikamenten herrührt, die zur Behandlung der Haarzellen-Leukämie eingesetzt werden.
Zweite Krebsarten, die bei Menschen gefunden werden, die wegen Haarzell-Leukämie behandelt wurden, umfassen unter anderem das Non-Hodgkin-Lymphom.
Quellen:
- Kaushansky K., et al., Hrsg. Haarzell-Leukämie. In: Williams Hämatologie. 9. Aufl. New York, NY: McGraw-Hill-Bildung; 2016. http://accessmedicine.mhmedical.com. Abgerufen am 18. Februar 2018.
- Grever MR, et al. Konsensrichtlinien für die Diagnose und Behandlung von Menschen mit klassischer Haarzell-Leukämie. Blut. 2017;129:553.
- Quest GR, et al. Klinische Merkmale und Diagnose der Haarzell-Leukämie. Best Practice & Research Klinische Hämatologie. 2015;28:180.
- Tallman MS, et al. Klinische Merkmale und Diagnose der Haarzell-Leukämie. http://www.uptodate.com/contents/search. Abgerufen am 18. Februar 2018.
- Hoffmann R. et al. Haarzell-Leukämie. In: Hämatologie: Grundlagen und Praxis. 7. Aufl. Philadelphia, Pennsylvania: Elsevier; 2018. https://www.clinicalkey.com. Abgerufen am 25. September 2017.
- Behandlung von Haarzellenleukämie (PDQ): Version für medizinische Fachkräfte. Nationales Krebs Institut. https://www.cancer.gov/types/leukemia/hp/hairy-cell-treatment-pdq#section/all. Abgerufen am 26. September 2017.
- Talmann MS. Behandlung der Haarzellenleukämie. https://www.uptodate.com/contents/search. Abgerufen am 18. Februar 2018.
- Notfallmanagement. Fort Washington, Pa.: Nationales umfassendes Krebsnetzwerk. http://www.nccn.org/professionals/physician_gls/f_guidelines.asp. Abgerufen am 28. September 2017.
- Haarzell-Leukämie. Fort Washington, Pa.: Nationales umfassendes Krebsnetzwerk. http://www.nccn.org/professionals/physician_gls/f_guidelines.asp. Abgerufen am 28. September 2017.
- Fragen Sie MayoExpert. Haarzell-Leukämie (HCL): Diagnose bis Erstbehandlung, Krankheitsrückfall (Erwachsener). Rochester, Minnesota: Mayo Foundation for Medical Education and Research; 2017.